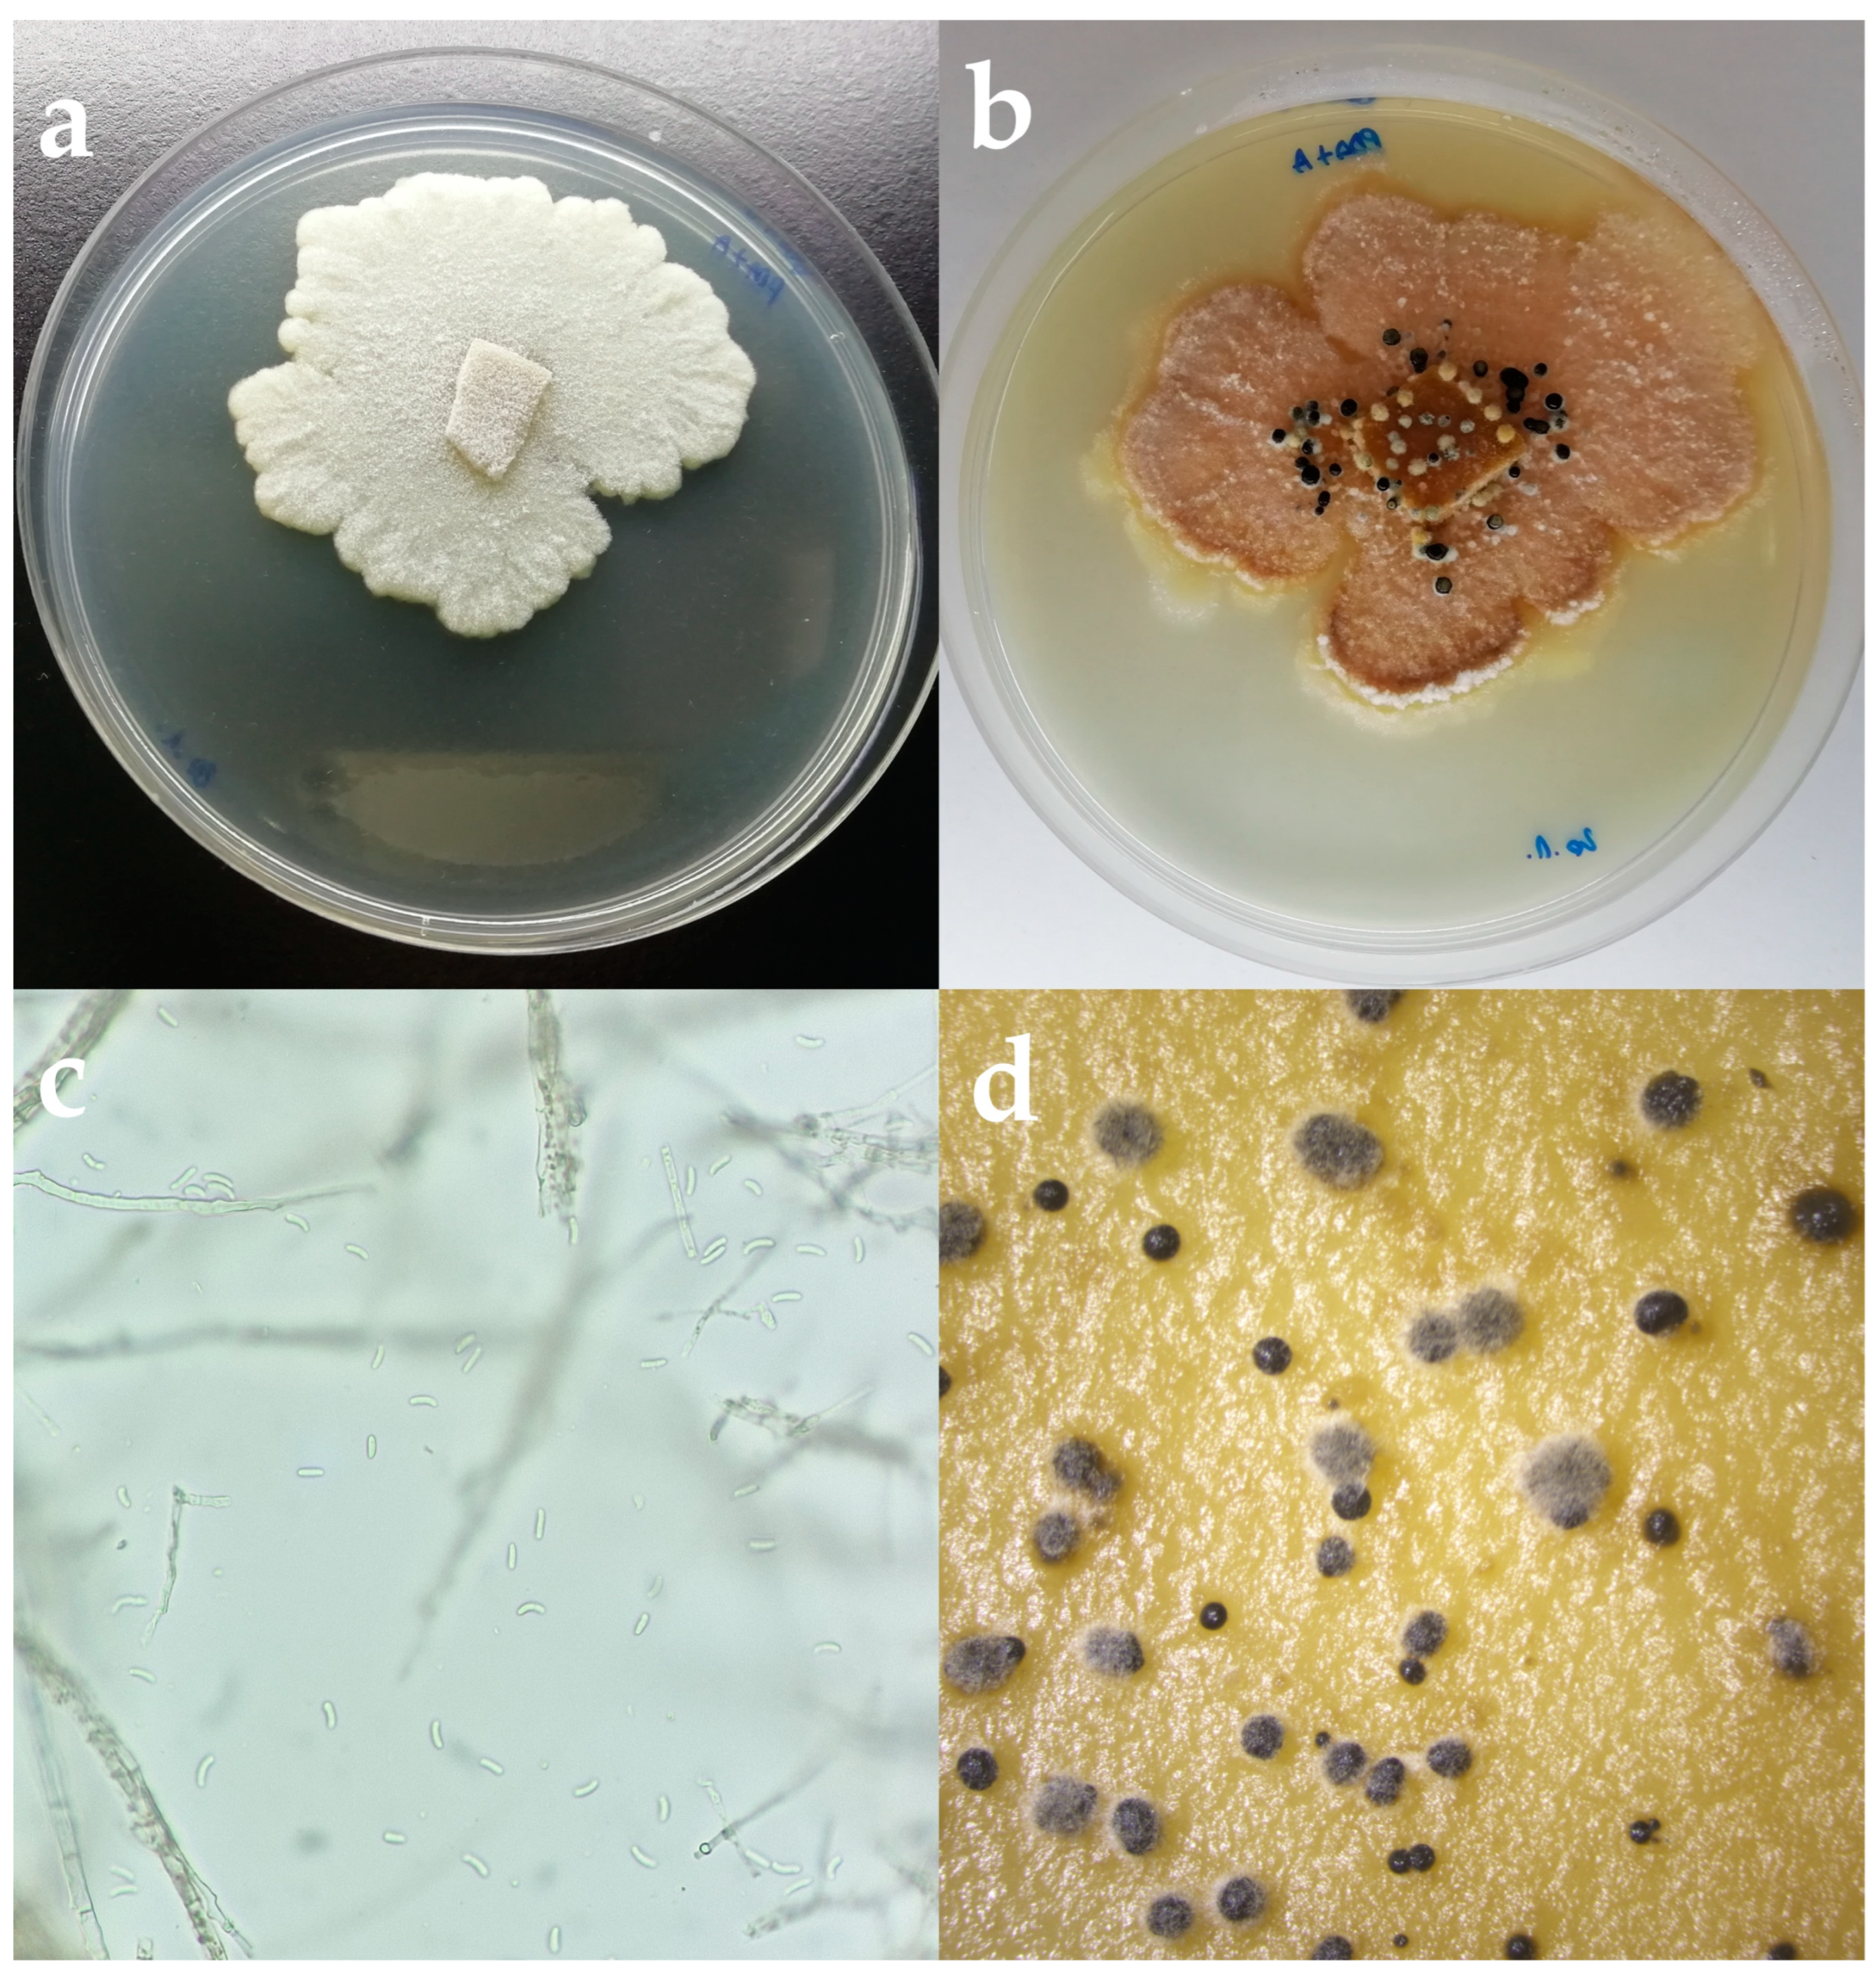

First Report of Olive Branch Dieback in Croatia Caused by Cytospora pruinosa Défago
Abstract
1. Introduction
2. Materials and Methods
2.1. Sampling and Fungal Isolation
2.2. Morphological Identification
2.3. Molecular Identification and Phylogenetic Analyses
2.4. Pathogenicity Tests
2.4.1. Pathogenicity on Detached Branches
2.4.2. Pathogenicity on Olive Trees
3. Results
3.1. Sampling and Fungal Isolation
3.2. Morphological Identification
3.3. Molecular Identification and Phylogenetic Analyses
3.4. Pathogenicity Tests of Isolate
4. Discussion
5. Conclusions
Supplementary Materials
Author Contributions
Funding
Institutional Review Board Statement
Informed Consent Statement
Data Availability Statement
Conflicts of Interest
References
- Rapoport, H.F.; Fabbri, A.; Sebastiani, L. Olive Biology. The Olive Tree Genome; Springer: Cham, Switzerland, 2016; pp. 13–25. [Google Scholar]
- Fraga, H.; Moriondo, M.; Leolini, L.; Santos, J.A. Mediterranean olive orchards under climate change: A review of future impacts and adaptation strategies. Agronomy 2021, 11, 56. [Google Scholar] [CrossRef]
- Ponti, L.; Gutierrez, A.P.; Ruti, P.M.; Dell’Aquila, A. Fine-scale ecological and economic assessment of climate change on olive in the Mediterranean Basin reveals winners and losers. Proc. Natl. Acad. Sci. USA 2014, 111, 5598–5603. [Google Scholar] [CrossRef]
- Mafrica, R.; Piscopo, A.; De Bruno, A.; Poiana, M. Effects of climate on fruit growth and development on olive oil quality in cultivar Carolea. Agriculture 2021, 11, 147. [Google Scholar] [CrossRef]
- Úrbez-Torres, J.R.; Lawrence, D.P.; Hand, F.P.; Trouillas, F.P. Olive twig and branch dieback in California caused by Cytospora oleicola and the newly described species Cytospora olivarum sp. nov. Plant Dis. 2020, 104, 1908–1917. [Google Scholar] [CrossRef]
- Food and Agriculture Organization of the United Nations. Available online: https://www.fao.org/faostat/en/#data/QCL (accessed on 5 June 2023).
- Gluhić, D. Jesenska gnojidba vinove loze i masline. Glas. Zast. Bilja 2020, 37, 97–110. [Google Scholar] [CrossRef]
- Žužić, I. Maslina i Maslinovo Ulje: Sa Posebnim Osvrtom na Istru; Olea, udruga maslinara Istarske županije; TIPOMAT: Velika Gorica, Croatia, 2008; pp. 1–380. [Google Scholar]
- Carlucci, A.; Raimondo, M.l.; Cibelli, F.; Phillips, A.J.I.; Lops, F. Pleurostomophora richardsiae, Neofusicoccum parvum and Phaeoacremonium aleophilum associated with a decline of olives in southern Italy. Phytopathol. Mediterr. 2013, 52, 517–527. [Google Scholar]
- Úrbez-Torres, J.R.; Peduto, F.; Vossen, P.M.; Krueger, W.H.; Gubler, W.D. Olive twig and branch dieback: Etiology, incidence, and distribution in California. Plant Dis. 2013, 97, 231–244. [Google Scholar] [CrossRef] [PubMed]
- Moral, J.; Agusti-Brisach, C.; Pérez-Rodríguez, M.; Xaviér, C.; Carmen-Raya, M.; Rhouma, A.; Trapero, A. Identification of fungal species associated with branch dieback of olive and resistance of table cultivars to Neofusicoccum mediterraneum and Botryosphaeria dothidea. Plant Dis. 2017, 101, 306–316. [Google Scholar] [CrossRef] [PubMed]
- Ivić, D.; Ivanović, A.; Miličević, T.; Cvjetković, B. Shoot necrosis of olive caused by Phoma incompta, a new disease of olive in Croatia. Phytopathol. Mediterr. 2010, 49, 414–416. [Google Scholar]
- Cvjetković, B. Mikoze i Pseudomikoze Voćnjaka i Vinove Loze; Zrinski: Čakovec, Croatia, 2010; pp. 5–534. [Google Scholar]
- Godena, S.; Ivić, D.; Goreta Ban, S. Uzročnici Djelomičnog ili Potpunog Sušenja Stabala Maslina; Priručnik o rezultatima VIP projekta; Institut za Poljoprivredu i Turizam: Poreč, Croatia, 2019; pp. 1–49. [Google Scholar]
- Kaliterna, J.; Miličević, T.; Ivić, D.; Benčić, D.; Mesić, A. First report of Diplodia seriata as causal agent of olive dieback in Croatia. Plant Dis. 2012, 96, 290. [Google Scholar] [CrossRef]
- Petrović, E.; Vrandečić, K.; Ćosić, J.; Kanižai Šarić, G.; Godena, S. First Report of Phaeoacremonium iranianum causing olive twig and branch dieback. Plants 2022, 11, 3578. [Google Scholar] [CrossRef] [PubMed]
- Kaliterna, J.; Miličević, T.; Benčić, D.; Mesić, A. First report of Verticillium wilt caused by Verticillium dahliae on olive trees in Croatia. Plant Dis. 2016, 100, 2526. [Google Scholar] [CrossRef]
- Adams, G.C.; Roux, J.; Wingfield, M.J. Cytospora species (Ascomycota, Diaporthales, Valsaceae): Introduced and native pathogens of trees in South Africa. Australasian Plant Pathol. 2006, 35, 521–548. [Google Scholar] [CrossRef]
- Adams, G.C.; Roux, J.; Wingfield, M.J.; Common, R.; Roux, J. Phylogenetic relationships and morphology of Cytospora species and related teleomorphs (Ascomycota, Diaporthales, Valsaceae) from Eucalyptus. Stud. Mycol. 2005, 52, 1–144. [Google Scholar]
- Lawrence, D.P.; Travadon, R.; Pouzoulet, J.; Rolshausen, P.E.; Wilcox, W.F.; Baumgartner, K. Characterization of Cytospora isolates from wood cankers of declining grapevine in North America, with the description of two new Cytospora species. Plant Pathol. 2017, 66, 713–725. [Google Scholar] [CrossRef]
- Ehrenberg, C.G. Sylvae Mycologicae Berolinenses; Formis Theophili Bruschcke: Berlin, Germany, 1818; pp. 1–52. [Google Scholar]
- Castlebury, L.A.; Rossman, A.Y.; Jaklitsch, W.J.; Vasilyeva, L.N. A preliminary overview of the Diaporthales based on large subunit nuclear ribosomal DNA sequences. Mycologia 2002, 94, 1017–1031. [Google Scholar] [CrossRef]
- Rossman, A.Y.; Farr, D.F.; Castlebury, L.A. A review of the phylogeny and biology of the Diaporthales. Mycoscience 2007, 48, 135–144. [Google Scholar] [CrossRef]
- Fan, X.; Bezerra, J.D.P.; Tian, C.M.; Crous, P.W. Families and genera of Diaporthalean fungi associated with canker and dieback of tree hosts. Persoonia 2018, 40, 119–134. [Google Scholar] [CrossRef] [PubMed]
- Encyclopedia of Life. 2023. Available online: https://eol.org/pages/5612 (accessed on 21 April 2023).
- Fan, X.L.; Bezerra, J.D.P.; Tian, C.M.; Crous, P.W. Cytospora (Diaporthales) in China. Persoonia 2020, 45, 1–45. [Google Scholar] [CrossRef]
- Grove, W. The British species of Cytospora. Bull. Misc. Inf. 1923, 1923, 1–30. [Google Scholar] [CrossRef]
- Spielman, L.J. A monograph of Valsa on hardwoods in North America. Can. J. Bot. 1985, 63, 1355–1378. [Google Scholar] [CrossRef]
- Adams, G.C.; Surve-Iyer, R.S.; Iezzoni, A.F. Ribosomal DNA sequence divergence and group I introns within the Leucostoma species L. cinctum, L. persoonii, and L. parapersoonii sp. nov., ascomycetes that cause Cytospora canker of fruit trees. Mycologia 2002, 94, 947–967. [Google Scholar]
- Wang, X.; Wei, J.; Huang, L.; Kang, Z. Re-evaluation of pathogens causing Valsa canker on apple in China. Mycologia 2011, 103, 317–324. [Google Scholar] [CrossRef] [PubMed]
- Lawrence, D.P.; Holland, L.A.; Nouri, M.T.; Tavadon, R.; Abramians, A.; Michailides, T.J.; Trouillas, F.P. Molecular phylogeny of Cytospora species associated with canker diseases of fruit and nut crops in California, with the descriptions of ten new species and one new combination. IMA Fungus 2018, 9, 333–369. [Google Scholar] [CrossRef] [PubMed]
- Fan, X.; Hyde, K.D.; Liu, M.; Liang, Y.; Tian, C. Cytospora species associated with walnut canker disease in China, with description of a new species C. gigalocus. Fungal Biol. 2015, 119, 310–319. [Google Scholar] [CrossRef] [PubMed]
- Zhu, H.Y.; Tian, C.M.; Fan, X. Multigene phylogeny and morphology reveal Cytospora spiraeae sp. nov. (Diaporthales, Ascomycota) in China. Phytotaxa 2018, 338, 49–62. [Google Scholar] [CrossRef]
- Monkai, J.; Tibpromma, S.; Manowong, A.; Mapook, A.; Norphanphoun, C.; Hyde, K.D.; Promputtha, I. Discovery of three novel Cytospora species in Thailand and their antagonistic potential. Diversity 2021, 13, 488. [Google Scholar] [CrossRef]
- Petrini, O. Fungal endophytes of tree leaves. In Microbial Ecology of Leaves; Andrews, J.H., Hirano, S.S., Eds.; Springer: New York, NY, USA, 1991; pp. 179–197. [Google Scholar]
- Lazarevic, J.; Menkis, A. Cytospora friesii and Sydowia polyspora are associated with the sudden dieback of Abies concolor in Southern Europe. Plant Prot. Sci. 2022, 58, 258–263. [Google Scholar] [CrossRef]
- Tekauz, A.; Patrick, Z. The role of twig infections on the incidence of perennial canker of peach. Phytopathology 1974, 64, 683–688. [Google Scholar] [CrossRef]
- Biggs, A.R. Integrated approach to controlling Leucostoma canker of peach in Ontario. Plant Dis. 1989, 73, 869–874. [Google Scholar] [CrossRef]
- Chang, L.S.; Iezzoni, A.F.; Adams, G.C.; Ewers, F.W. Hydraulic conductance in susceptible versus tolerant peach seedlings infected with Leucostoma persoonii. J. Am. Soc. Hortic. Sci. 1991, 116, 831–834. [Google Scholar] [CrossRef]
- White, T.J.; Bruns, T.D.; Lee, S.B.; Taylor, J.W. 38—Amplification and direct sequencing of fungal ribosomal RNA Genes for phylogenetics. In PCR—Protocols and Applications—A Laboratory Manual; Innis, M.A., Gelfand, D.H., Sninsky, J.J., White, T.J., Eds.; Academic Press: Cambridge, MA, USA, 1990; pp. 315–322. [Google Scholar]
- Glass, N.L.; Donaldson, G.C. Development of primer sets designed for use with the PCR to amplify conserved genes from filamentous ascomycetes. Appl. Environ. Microbiol. 1995, 61, 1323–1330. [Google Scholar] [CrossRef] [PubMed]
- Saitou, N.; Nei, M. The neighbor-joining method: A new method for reconstructing phylogenetic trees. Mol. Biol. Evol. 1987, 4, 406–425. [Google Scholar]
- Felsenstein, J. Confidence limits on phylogenies: An approach using the bootstrap. Evolution 1985, 39, 783–791. [Google Scholar] [CrossRef] [PubMed]
- Tamura, K.; Nei, M.; Kumar, S. Prospects for inferring very large phylogenies by using the neighbor-joining method. Proc. Natl. Acad. Sci. USA 2004, 101, 11030–11035. [Google Scholar] [CrossRef]
- Tamura, K.; Stecher, G.; Kumar, S. MEGA 11: Molecular Evolutionary Genetics Analysis Version 11. Mol. Biol. Evol. 2021, 38, 3022–3027. [Google Scholar] [CrossRef]
- van Dyk, M.; Spies, C.F.J.; Mostert, L.; van der Rijst, M.; du Plessis, I.L.; Moyo, P.; van Jaarsveld, W.J.; Haleen, F. Pathogenicity testing of fungal isolates associated with olive trunk diseases in South Africa. Plant Dis. 2021, 105, 4060–4073. [Google Scholar] [CrossRef]
- Rumbos, I.C. Cytospora oleina causing canker and dieback of olive in Greece. Plant Pathol. 1988, 37, 441–444. [Google Scholar] [CrossRef]
- Kowalski, T.; Bilanski, P.; Kraj, W. Pathogenicity of fungi associated with ash dieback towards Fraxinus excelsior. Plant Pathol. 2017, 66, 1228–1238. [Google Scholar] [CrossRef]
- Rajtar, N.N.; Held, B.W.; Blanchette, R.A. Fungi from galleries of the emerald ash borer produce cankers in ash trees. Forests 2021, 12, 1509. [Google Scholar] [CrossRef]
- Miller, S.T.; Otto, K.L.; Sterle, D.; Minas, I.S.; Stewart, J.E. Preventive fungicidal control of Cytospora leucostoma in peach orchards in Colorado. Plant Dis. 2019, 103, 1138–1147. [Google Scholar] [CrossRef] [PubMed]
- Holland, L.A.; Travadon, R.; Lawrence, D.P.; Nouri, M.T.; Trouillas, F. Evaluation of pruning wound protection products for the management of almond canker diseases in California. Plant Dis. 2021, 105, 3365–3375. [Google Scholar] [CrossRef] [PubMed]
- Miller, S.T.; Sterle, D.; Minas, I.S.; Stewart, J.E. Exploring fungicides and sealants for management of Cytospora plurivora infections in western Colorado peach production systems. Crop Prot. 2021, 146, 105654. [Google Scholar] [CrossRef]
- Ren, J.H.; Li, H.; Wang, Y.F.; Ye, J.R.; Yan, A.Q.; Wu, X.W. Biocontrol potential of an endophytic Bacillus pumilus JK-SX001 against poplar canker. Biol. Control. 2013, 67, 421–430. [Google Scholar] [CrossRef]
- Bertrant, P.F.; English, H. Release and dispersal of conidia of Valsa leucostoma. Phytopathology 1976, 66, 987–991. [Google Scholar] [CrossRef]

Disclaimer/Publisher’s Note: The statements, opinions and data contained in all publications are solely those of the individual author(s) and contributor(s) and not of MDPI and/or the editor(s). MDPI and/or the editor(s) disclaim responsibility for any injury to people or property resulting from any ideas, methods, instructions or products referred to in the content. |
© 2023 by the authors. Licensee MDPI, Basel, Switzerland. This article is an open access article distributed under the terms and conditions of the Creative Commons Attribution (CC BY) license (https://creativecommons.org/licenses/by/4.0/).
Share and Cite
Petrović, E.; Vrandečić, K.; Ivić, D.; Ćosić, J.; Godena, S. First Report of Olive Branch Dieback in Croatia Caused by Cytospora pruinosa Défago. Microorganisms 2023, 11, 1679. https://doi.org/10.3390/microorganisms11071679
Petrović E, Vrandečić K, Ivić D, Ćosić J, Godena S. First Report of Olive Branch Dieback in Croatia Caused by Cytospora pruinosa Défago. Microorganisms. 2023; 11(7):1679. https://doi.org/10.3390/microorganisms11071679
Chicago/Turabian StylePetrović, Elena, Karolina Vrandečić, Dario Ivić, Jasenka Ćosić, and Sara Godena. 2023. "First Report of Olive Branch Dieback in Croatia Caused by Cytospora pruinosa Défago" Microorganisms 11, no. 7: 1679. https://doi.org/10.3390/microorganisms11071679
APA StylePetrović, E., Vrandečić, K., Ivić, D., Ćosić, J., & Godena, S. (2023). First Report of Olive Branch Dieback in Croatia Caused by Cytospora pruinosa Défago. Microorganisms, 11(7), 1679. https://doi.org/10.3390/microorganisms11071679

